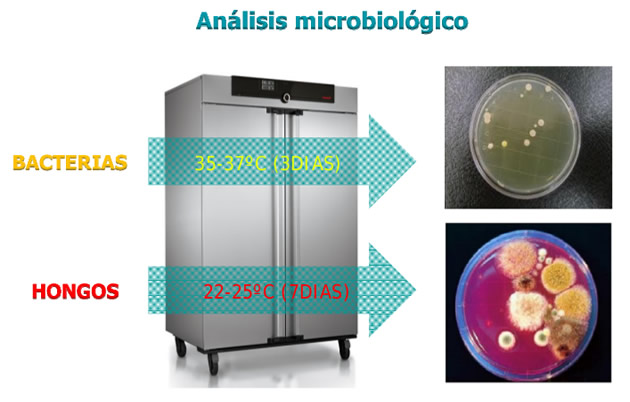
analisis microbiologico

La calidad del aire interior (CAI) es uno de los aspectos que considera la Ley de Prevención de Riesgos Laborales para mantener los espacios de trabajo en condiciones saludables. Uno de los riesgos dentro del ámbito de la CAI es la contaminación del ambiente interior por agentes biológicos. Este fué el tema que expuso Ambientalys, empresa especializada en análisis, consultoría y formación en CAI, durante las V Jornadas de PRL de entorno sanitario en la Comunidad Valenciana.
Las V Jornadas de Prevención de Riesgos Laborales de entorno sanitario en la Comunidad Valenciana, celebradas el pasado 11 de junio en el Hospital Universitario de La Ribera, fueron un foro de debate para abordar experiencias en vigilancia de la salud en Prevención de Riesgos Laborales.
Entre otros muchos temas tratados, destacamos la ponencia “Calidad de Ambientes Interiores:Normativa Aplicable. Control de Agentes Biológicos" realizada por Enrique Mira, director de Ambientalys, que expuso las características de la contaminación ambiental biológica en interiores, los métodos y parámetros a tener en cuenta para evaluarla y los limites de contaminación establecidos por la normativa actual.
La contaminación biológica en los ambientes interiores viene dada, según explicó Mira, por contaminantes ambientales de procedencia biológica, tales como microorganismos, fragmentos, toxinas, partículas de desecho, virus, bacterias, hongos o ácaros, que pueden ser causantes de enfermedades infecciosas, alergias, efectos tóxicos, molestias irritativas, jaquecas, etc en los usuarios del edificio.
Para ayudar a mantener un ambiente interior sano, la actual normativa, el RD 238/2013 que modifica el RITE (Reglamento de Instalaciones Térmicas en los Edificios), establece la obligatoriedad de dos nuevas operaciones incluidas dentro del mantenimiento preventivo de las instalaciones: la revisión de la red de conductos de aire (según la norma UNE 100012) y la revisión de la calidad ambiental interior (según la norma UNE 171330).
Dichas operaciones, realizadas por especialistas en Higiene (TSCAI + TMCAI + SVAA), incluyen una inspección visual, microbiológica y de la materia particulada. Los parámetros que son evaluados de forma obligatoria son: temperatura, humedad relativa, partículas, hongos y bacterias, mientras que existen otros factores adicionales como el ruido, COVs, electricidad estática, iluminación, ozono o fibras.
Los agentes biológicos implicados en la CAI
En su ponencia Mira destacó las bacterias, los hongos y los ácaros como principales contaminantes biológicos en interiores.
Las bacterias, presentes en todos los ambientes acuáticos y terrestres, pueden acceder a los interiores con el agua, las personas, animales, el aire, a través de ventanas, puertas, sistemas de climatización u otros sistemas del edificio. Además de enfermedades infecciosas, las bacterias pueden producir endotoxinas, sustancias producto de su metabolismo, que tienen efectos tóxicos.
La presencia de hongos en ambientes interiores está condicionada por factores como la humedad y los sustratos donde crecen; paredes, muebles, papel, alfombras, etc. Las esporas de los hongos pueden causar alergias y, igual que las bacterias, estos organismos también producen sustancias con efectos tóxicos, las micotoxinas.
Los ácaros, diminutos arácnidos capaces de poner entre 20 y 50 huevos cada 3 semanas, depositan gran cantidad de heces en el ambiente que son responsables de alergias en humanos.
Asi pues, los agentes biológicos pueden causar 4 tipos básicos de enfermedades en los ocupantes de un edificio: enfermedades infecciosas, alergias, efectos tóxicos y efectos irritativos o Sindrome del Edificio Enfermo (conjunto de molestias originadas por la contaminación del aire en espacios cerrados: jaquecas, nauseas, irritacion de ojos,rinitis, etc)
Análisis y evaluación de la contaminación biológica en interiores
Existe gran variedad de técnicas e instrumentos para el análisis de los agentes biológicos en ambientes interiores, ya sea en superficie o en el ambiente.
Enrique Mira expuso las diferentes técnicas para la recogida de muestras. En superficie destacó el Frotis, las placas RODAC y los laminocultivos. En el caso de los ácaros, se utilizaria la aspiración y posteriormente la flotación; suspensión de la muestra en etanol, extracción de ácaros y observación al microscopio.
Para recoger muestras en el ambiente se utilizaria la impactación (paso de aire a través de unos pequeños orificios sobre placas. SAS (Surface Air Sample)), la sedimentación (depósito de partículas ambientales sobre placa Petri por efecto de la gravedad) y el borboteo (borboteo de un volumen de aire a través de un medio acuoso contenido en un frasco lavador)
Con la información obtenida, el tipo de análisis microbiológico a desarrollar depende de la información que se quiera obtener; cuantitativa (recuento de agentes biológicos y sus productos), cualitativa (identificación o búsqueda de una especie de microorganismo, o comparativa entre distintos ambientes.
Límites
Finalmente, en la ponencia se expuso el tema de los limites de contaminación biológica a tener en cuenta para mantener un ambiente interior saludable. La normativa actual sobre calidad de ambientes interiores (UNE 171330-2:2009), establece los siguientes límites para bacterias y hongos:
| SAS (por impactación) | Bacterias | <800 ufc/m³ |
| Hongos |
<200 ufc/m³ |
| RELACIÓN INTERIOR / EXTERIOR | BACTERIAS | HONGOS |
| Exterior | 1 | 1 |
| Interior: en salida de difusores de impulsión de aire | < 1,5 | < 0,5 |
| Interior: en área ocupada según la definición de esta norma | < 1,75 | < 0,75 |
Para los ácaros, el limite consensuado de forma general esta alrededor de unos 100 ácaros/gramo de polvo
SOBRE AMBIENTALYS CONSULTORÍA Y ANÁLISIS
Ambientalys Consultoría y Análisis SL nace para cubrir las necesidades detectadas en el sector de la sanidad ambiental, principalmente como soporte técnico a los profesionales del mundo de la higiene ambiental, en tres grandes áreas: higiene alimentaria, control de aguas y ambientes interiores.
Ambientalys, especializada en Análisis, Consultoría y Formación , es una empresa comprometida con la calidad y el respeto al medio ambiente, estando acreditada por ENAC según la norma ISO17025 y certificada en ISO 9001.
